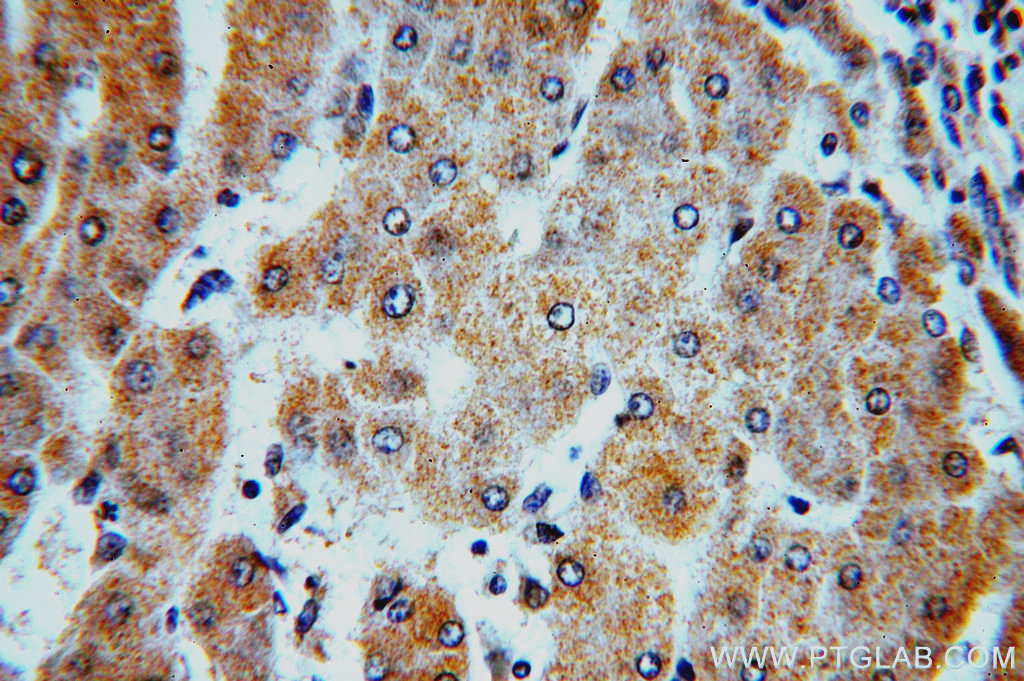
19423-1-ap;hepatocirrhosis

hepato

12) step 1: hepato-biliary system
图片尺寸488x500
临床药学培训---肝功能检验ppt
图片尺寸1080x810
乙肝患者能生小孩吗?
图片尺寸640x450
护肝排毒剂hepatoboost
图片尺寸1414x2000
heverthepatos水飞蓟保肝护肝片100粒
图片尺寸250x250
12) step 1: hepato-biliary system
图片尺寸500x333
预订 hepato-biliary-pancreatic surgery and liver transplantation
图片尺寸342x499
rileys essentials hepato support with milk thistle for d
图片尺寸880x573
【4周达】hepato protective studies on three traditional indian
图片尺寸800x800
19423-1-ap;hepatocirrhosis
图片尺寸1024x681
weleda维蕾德 hepatodoron 100 tablets
图片尺寸298x298
hepatoblasts and method of isolating same
图片尺寸1181x2752
self‐renewal of hepatoblasts under chemically defined
图片尺寸1285x826
hepatospecific effects of fructose on c-jun nh2-terminal kinase
图片尺寸784x1280
【预订】handbook of hepato-pancreato-biliary
图片尺寸369x499
hepatospecific effects of fructose on c-jun nh2-terminal kinase
图片尺寸809x1280
hepatoven tm, 60 capsules, vegan product - premier detoxifi
图片尺寸880x573
agent for treating hepato biliary diseases
图片尺寸944x337
【4周达】hepato-morpholoy and biochemical studies on the liver
图片尺寸800x800
预订hepato-pancreato-biliary surgery
图片尺寸267x400